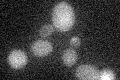
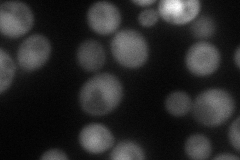
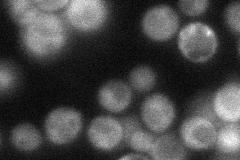
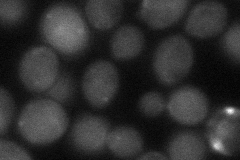
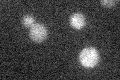

View description
RNase of the DEDD superfamily, subunit of the Ccr4-Not complex that mediates 3' to 5' mRNA deadenylation
Localization:
Intensity:
Fold change:
Significance:
-
C’ GFP library in SD
below threshold17.63 -
N' NOP1pr-GFP in SD

cytosol83.932 -
N' TEF2pr-mCherry in SD
nucleus78.6219 -
N' NATIVEpr-GFP in SD
cytosol33.7154 -
N' TEF2pr-VC and Cyto-VN in SD
cytosol46.9721 -
C’ GFP library in SD+DTT

cytosol15.240.86No -
C’ GFP library in SD+H2O2

cytosol19.331.09No -
C’ GFP library in Starvation Media
cytosol15.780.89No -
C’ GFP library on the background of Pup2-DaMP

below threshold -
C’ GFP library on the background of CCT mutant

below threshold17.53920.99439No
